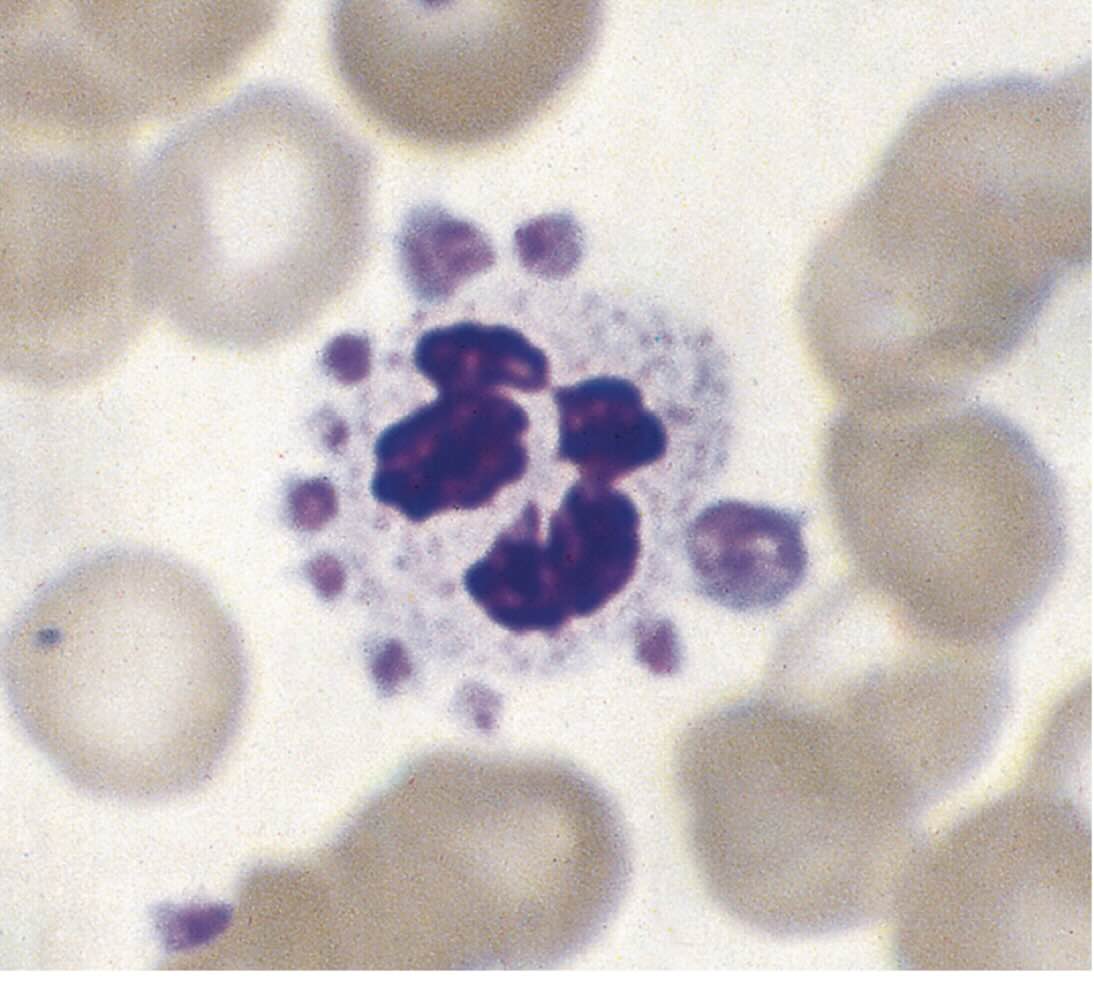
پدیده اقماری پلاکت
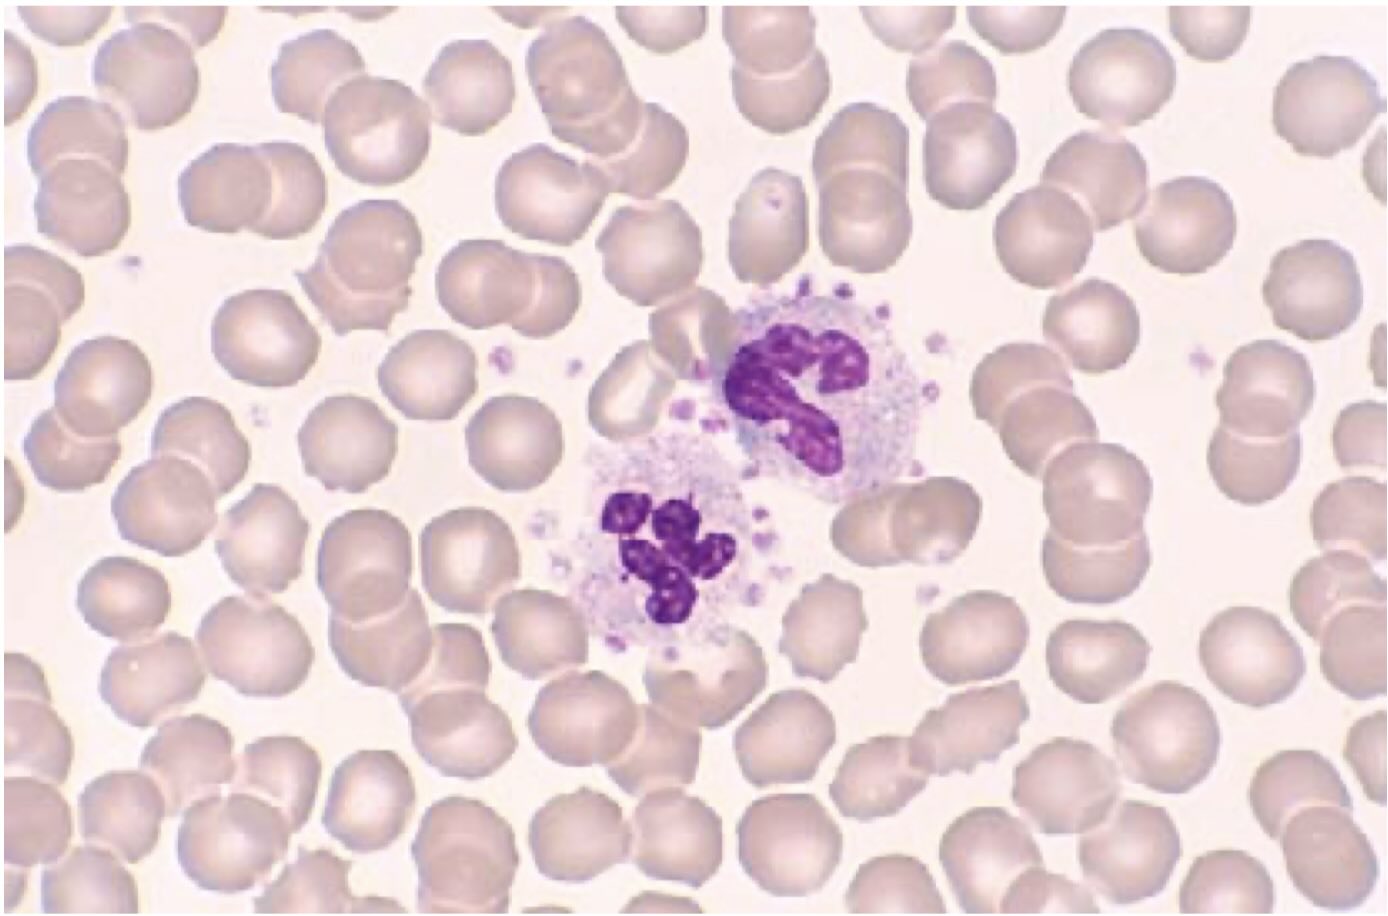
پدیده اقماری پلاکت

پدیده اقماری پلاکت (Platelet Satellitism) چیست؟ | راهنمای کامل تفسیر و تشخیص آزمایشگاهی
پدیده اقماری پلاکت یک آرتیفکت آزمایشگاهی نادر است که در آن پلاکتها بهصورت حلقهای یا نیمحلقهای اطراف نوتروفیلها در نمونههای حاوی EDTA تجمع میکنند و باعث ترومبوسیتوپنی کاذب در گزارش CBC میشوند. این پدیده کاملاً in vitro است، در بدن بیمار رخ نمیدهد، اما از نظر تشخیصی بسیار مهم است چون میتواند منجر به تشخیص اشتباه ITP و درمانهای غیرضروری شود.
جهت عضویت در کانال آموزشی در تلگرام به لینک زیر مراجعه کنید:
https://t.me/hematology_education
فهرست مطالب پدیده اقماری پلاکت
پدیده اقماری پلاکت چیست؟
مکانیسم ایجاد پدیده اقماری پلاکت
ظاهر پدیده اقماری پلاکت در اسمیر خون محیطی
تأثیر Platelet Satellitism بر نتایج CBC
چگونه Platelet Satellitism را تشخیص دهیم؟
موارد افتراقی
افراد مستعد Platelet Satellitism
تأثیر بالینی و اهمیت تشخیصی
سخن پایانی
سوالات متداول
منابع و مقالات برای مطالعه بیشتر
پدیده اقماری پلاکت چیست؟
در این بخش، Platelet Satellitism و نقش آن بهعنوان یک آرتیفکت آزمایشگاهی در تفسیر CBC را مرور میکنیم تا جایگاه آن در هماتولوژی تشخیصی روشنتر شود.
پدیده ی اقماری پلاکت (Platelet Satellitism) یک آرتیفکت آزمایشگاهی است که در آن پلاکتها بهصورت هالهوار، حلقهای یا نیمحلقهای اطراف نوتروفیلها تجمع میکنند. این پدیده تقریباً همیشه در نمونههای حاوی EDTA رخ میدهد و باعث ترومبوسیتوپنی کاذب در گزارش CBC میشود.
در بدن بیمار هیچ اتفاق غیرعادی رخ نمیدهد؛ این پدیده کاملاً in vitro است و اهمیت بالینی از نظر بیماریزایی ندارد، اما اهمیت تشخیصی بالایی دارد چون میتواند پزشک را به اشتباه بیندازد.
هرگاه در بیمار بدون علائم خونریزی، پلاکت بسیار پایین گزارش شود، یکی از اولین احتمالاتی که باید در ذهن کارشناس آزمایشگاه مطرح شود، پدیده اقماری پلاکت است.
برای آشنایی جامعتر با آزمایشهای پایهای خون و مغز استخوان میتوانید مقاله
دوره جامع آموزش تصویری هماتولوژی فصل پنج : آزمایش های پایهای خون و مغز استخوان
را در سایت هیاموستیکا مطالعه کنید.
مکانیسم ایجاد پدیده اقماری پلاکت
مکانیسم ایحاد این پدیده مبتنی بر ترکیب اثر EDTA، تغییرات غشایی نوتروفیلها و حضور آنتیبادی IgG است و بهخوبی توضیح میدهد که چرا Platelet Satellitism یک پدیده کاملاً in vitro محسوب میشود.
مکانیسم دقیق بهطور کامل شناخته نشده، اما سه عامل کلیدی نقش دارند:
۱. نقش EDTA
EDTA با شلاتهکردن کلسیم باعث تغییراتی در غشای نوتروفیل میشود.
این تغییرات سبب میشود:
- گیرندههای FcγRIII (CD16) روی سطح نوتروفیلها بیشتر در دسترس قرار گیرد
- نوتروفیلها به پلاکتها نزدیکتر و مستعد اتصال شوند
بدون EDTA معمولاً چنین تغییراتی رخ نمیدهد.
۲. نقش آنتیبادی IgG در ایجاد پدیده پلاکت اقماری
برخی افراد در خون خود آنتیبادی IgG دارند که رفتار Dual-binding دارد:
- یک بخش آن به گیرنده Fc روی نوتروفیل متصل میشود
- بخش دیگر آن به پلاکت اتصال پیدا میکند
این آنتیبادی مانند یک پل مولکولی عمل کرده و پلاکتها را دور نوتروفیل جمع میکند.
نکته مهم:
این آنتیبادی در حضور EDTA فعالتر میشود و در نمونه سیترات یا هپارین این چسبندگی رخ نمیدهد.
۳. وابستگی کامل پدیده به شرایط آزمایشگاهی
چون این پدیده فقط در لولههای EDTA رخ میدهد و هیچ نسخهای از آن در بدن وجود ندارد، آن را آرتیفکت in vitro میدانند.
در تفسیر نتایج CBC، هر زمان که ترومبوسیتوپنی همراه با EDTA بهعنوان ضدانعقاد اصلی باشد، توجه به Platelet Satellitism اهمیت زیادی دارد.
ظاهر پدیده در اسمیر خون محیطی
تشخیص Platelet Satellitism تا حد زیادی وابسته به مشاهده دقیق اسمیر خون محیطی است؛ Platelet Satellitism الگوی بسیار مشخصی در کنار نوتروفیلها ایجاد میکند.
در رنگآمیزی Wright یا Giemsa، ویژگیهای زیر دیده میشود:
- پلاکتها به شکل حلقه یا نیمحلقه دور نوتروفیل جمع شدهاند
- در برخی نوتروفیلها تجمع شدیدتر دیده میشود
- پلاکت آزاد در بستر اسمیر نسبتاً کم است
- سایر سلولها معمولاً طبیعی هستند
این ظاهر کاملاً اختصاصی است و با Clumping پلاکتی اشتباه نمیشود. در زیر اشکال مختلفی از این پدیده را مشاهده می کنید:
Platelet Satellitism

برای آشنایی دقیق با روش رنگآمیزی، پیشنهاد میشود مقاله
روش رنگ آمیزی رایت گیمسا (Wright-Giemsa Staining Method): آموزش کامل مراحل، نکات و کنترل کیفی
را در سایت Heamostica مطالعه کنید.
تأثیر Platelet Satellitism بر نتایج CBC
یکی از مهمترین پیامدهای Platelet Satellitism، ایجاد ترومبوسیتوپنی کاذب در گزارش CBC و ظاهر غیرطبیعی در چارتهای دستگاه هماتولوژی است.
۱. کاهش کاذب پلاکت (Pseudo-thrombocytopenia)
چون پلاکتهای چسبیدهشده به نوتروفیلها توسط آنالایزر بهعنوان پلاکت آزاد شمرده نمیشوند، مقدار پلاکت بهطور کاذب پایین گزارش میشود.
۲. ایجاد FLAG در دستگاه
بسته به نوع دستگاه، احتمال مشاهده هشدارهای زیر وجود دارد:
- PLT abnormal distribution
- PLT clumps
- WBC interference
- Suspected giant platelets
۳. تأثیر بر Scattergram
تجمع پلاکت اطراف WBC ممکن است باعث تغییر الگوی پراکندگی نقاط در نمودارهای دستگاه شود.
چگونه Platelet Satellitism را تشخیص دهیم؟
تشخیص صحیح Platelet Satellitism در آزمایشگاه، نیازمند ترکیب بررسی اسمیر خون محیطی، ارزیابی دوباره CBC و گاهی تکرار نمونهگیری با ضدانعقادهای دیگر است.
۱. بررسی اسمیر خون محیطی
روش قطعی و اصلی تشخیص.
مشاهده تجمع پلاکتی بهصورت حلقهای دور نوتروفیلها، تشخیص را تأیید میکند.
۲. تکرار تست در لوله سیترات یا هپارین
اگر پلاکت در لوله سیترات به حالت طبیعی بازگشت و Satellitism مشاهده نشد، تشخیص قطعی است.
(در لوله سیترات معمولاً مقدار پلاکت ×1.1 اصلاح میشود.)
۳. شمارش دستی پلاکت
اگر نیاز باشد، شمارش دستی برای برآورد دقیقتر استفاده میشود.
در حضور Platelet Satellitism بهتر است در گزارش آزمایش، به ترومبوسیتوپنی کاذب و استفاده از نمونه سیترات برای شمارش صحیح پلاکت اشاره شود تا از تصمیمات درمانی اشتباه جلوگیری گردد.
موارد افتراقی
برای جلوگیری از اشتباه در تشخیص این پدیده باید Platelet Satellitism از سایر آرتیفکتها و اختلالات پلاکتی مشابه افتراق داده شود.
۱. Clumping پلاکتی
- پلاکتها به هم میچسبند، نه دور نوتروفیل
- الگوی حلقهای ندارد
- معمولاً ناشی از EDTA-dependent platelet agglutination است
۲. Giant Platelets
پلاکتها بزرگ هستند اما چسبندگی به نوتروفیل ندارند.
۳. Platelet Phagocytosis
در آن پلاکتها توسط نوتروفیل بلعیده میشوند، نه اینکه مرتب دور آن بچسبند.
افراد مستعد
اگرچه Platelet Satellitism نادر است، اما در برخی گروههای بیماران بیشتر دیده میشود و شناخت این گروهها به تشخیص سریع Platelet Satellitism کمک میکند.
Platelet Satellitism بسیار نادر است و در شرایط زیر بیشتر دیده میشود:
- بیماریهای خودایمنی (مانند لوپوس)
- بیماریهای لنفوپرولیفراتیو (مثل CLL)
- برخی عفونتها
- افراد کاملاً سالم بدون سابقه بیماری
تأثیر بالینی و اهمیت تشخیصی پدیده اقماری پلاکت
از نظر بالینی، Platelet Satellitism بیماری محسوب نمیشود، اما Platelet Satellitism از نظر تفسیر نتایج آزمایشگاهی اهمیت زیادی دارد.
گرچه از نظر پزشکی بیماری نیست و خطر ندارد، اما:
- میتواند پزشک را به اشتباه بیندازد
- ممکن است باعث تشخیص اشتباه ITP شود
- میتواند بیمار را بیدلیل بستری کند
- حتی ممکن است منجر به تزریق پلاکت یا IVIG شود
بنابراین تشخیص آن بسیار حیاتی است.
سخن پایانی در مورد پدیده اقماری پلاکت
این پدیده یک آرتیفکت مهم و نادر آزمایشگاهی است که باعث ترومبوسیتوپنی کاذب در دستگاه CBC میشود. تشخیص آن مستلزم بررسی اسمیر خون و در صورت نیاز تکرار تست با لوله سیترات است.
شناخت این پدیده برای جلوگیری از تشخیص غلط و درمانهای بیمورد ضروری است.
سوالات متداول درباره پدیده اقماری پلاکت
۱. پدیده اقماری پلاکت چیست؟
پدیده اقماری پلاکت یا Platelet Satellitism یک آرتیفکت آزمایشگاهی است که در آن پلاکتها بهصورت حلقهای یا نیمحلقهای اطراف نوتروفیلها در نمونههای حاوی EDTA تجمع میکنند و باعث ترومبوسیتوپنی کاذب در CBC میشوند.
۲. آیا پدیده اقماری پلاکت برای بیمار خطرناک است؟
خیر. پدیده اقماری پلاکت یک پدیده کاملاً in vitro است و در بدن بیمار رخ نمیدهد. مشکل اصلی آن ایجاد ترومبوسیتوپنی کاذب و امکان تشخیص اشتباه است، نه خونریزی واقعی یا تخریب پلاکت.
۳. علت اصلی ایجاد Platelet Satellitism چیست؟
این پدیده به علت ترکیب اثر EDTA بر غشای نوتروفیلها و حضور آنتیبادی IgG ایجاد میشود. آنتیبادی IgG نقش پل را بین نوتروفیل و پلاکتها ایفا میکند و باعث تجمع پلاکتها به دور نوتروفیل میشود.
۴. پدیده اقماری پلاکت چگونه باعث کاهش کاذب پلاکت میشود؟
دستگاه هماتولوژی پلاکتهایی را که به نوتروفیلها چسبیدهاند بهعنوان پلاکت آزاد نمیشمارد، بنابراین تعداد پلاکت کمتر از مقدار واقعی گزارش میشود و ترومبوسیتوپنی کاذب ایجاد میگردد.
۵. برای تشخیص پدیده اقماری پلاکت چه باید کرد؟
مهمترین اقدام، بررسی اسمیر خون محیطی است. مشاهده تجمع پلاکتها بهصورت حلقهای دور نوتروفیلها تشخیص را تأیید میکند. در صورت نیاز، CBC در لوله سیترات یا هپارین تکرار میشود.
۶. تفاوت پدیده اقماری پلاکت با Clumping پلاکتی چیست؟
در Clumping پلاکتی، پلاکتها به یکدیگر میچسبند و معمولاً به صورت تودهای در اسمیر دیده میشوند، در حالی که در پدیده اقماری پلاکت، پلاکتها بهطور منظم به شکل حلقهای دور نوتروفیلها تجمع میکنند.
۷. در صورت وجود Platelet Satellitism، عدد صحیح پلاکت چگونه گزارش شود؟
در این موارد توصیه میشود نمونه جدید در لوله سیترات گرفته شده و پلاکت در آن سنجیده شود. سپس در گزارش ذکر شود که ترومبوسیتوپنی در نمونه EDTA کاذب بوده و عدد صحیح براساس نمونه سیترات است.
۸. چه بیمارانی بیشتر دچار پدیده اقماری پلاکت میشوند؟
این پدیده در بیماران با بیماریهای خودایمنی، اختلالات لنفوپرولیفراتیو مانند CLL و برخی عفونتها بیشتر دیده میشود، اما میتواند در افراد کاملاً سالم نیز رخ دهد.
۹. آیا پدیده اقماری پلاکت نیاز به درمان دارد؟
خیر. پدیده اقماری پلاکت خود یک بیماری نیست و درمان خاصی ندارد. تنها اقدام لازم، تشخیص درست آن در آزمایشگاه و جلوگیری از تفسیر اشتباه نتایج پلاکت است.
۱۰. چرا آشنایی آزمایشگاه با پدیده اقماری پلاکت مهم است؟
آشنایی با این پدیده از گزارش ترومبوسیتوپنی کاذب، تشخیص اشتباه ITP، بستری غیرضروری و درمانهای پرهزینهای مانند IVIG یا تزریق پلاکت جلوگیری میکند و کیفیت تفسیر آزمایش CBC را بهطور قابلتوجهی افزایش میدهد.
منابع و مقالات برای مطالعه بیشتر در مورد پدیده اقماری پلاکت
NCBI – National Center for Biotechnology Information
PubMed – Platelet Satellitism Articles
- کتابهای مرجع هماتولوژی آزمایشگاهی مانند Henry’s Clinical Diagnosis and Management by Laboratory Methods
- مقالات مروری در زمینه Pseudothrombocytopenia و Platelet Satellitism در مجلات هماتولوژی و لابراتوار.
“`
